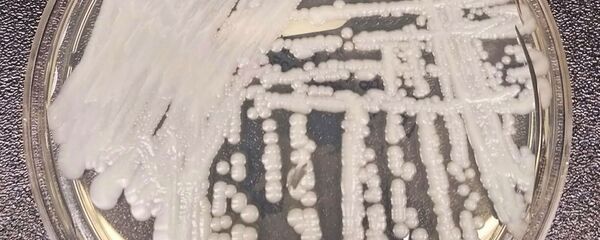
Candida auris - Sputnik Mundo

¿Por qué el superhongo 'Candida auris' encontrado en Brasil es difícil de detectar y curar?
18:24 GMT 11.12.2020 (actualizado: 14:26 GMT 03.06.2024)

© REUTERS / Maxim Shemetov
Síguenos en
Un posible primer caso del superhongo 'Candida auris' ha sido registrado en Brasil. En una entrevista con Sputnik, un infectólogo explica que es un "agente oportunista" que penetra en el cuerpo cuando es más vulnerable.
El hongo Candida auris fue descubierto en 2009 y ahora se ha extendido a más de 30 países. Es resistente a muchos medicamentos y mortal en alrededor del 39% de los casos, por lo que llegó a conocerse como un superhongo.
"Por lo general, una persona se contagia cuando se rompe alguna barrera, se coloca un catéter en el cuerpo, durante la cirugía o cuando las bacterias de nuestro cuerpo mueren porque tomamos antibióticos y estos hongos proliferan", revela a Sputnik Alessandro Comarú Pasqualotto, profesor de la Universidad Federal de Ciencias de la Salud en Porto Alegre, Rio Grande do Sul, al destacar que es un "agente oportunista".
Según el boletín de la Agencia Nacional de Vigilancia Sanitaria de Brasil (Anvisa), el primer diagnóstico de la enfermedad en el país se produjo en un adulto hospitalizado en el estado de Bahía y fue confirmado por el Laboratorio del Hospital de Clínicas de la Facultad de Medicina de la Universidad de Sao Paulo. El organismo señala que el hongo "representa una grave amenaza para la salud mundial".
Siendo un hongo del género Candida, puede causar una candidiasis que puede presentarse de manera superficial, por ejemplo, en la piel, o ser profunda. La infección puede empeorar si pasa a la sangre, afirma el epidemiólogo Guilherme Werneck, profesor del Instituto de Medicina Social de la Universidad Estatal de Río de Janeiro.
"La infección por 'Candida auris' (...) puede ser bastante grave si pasa a la sangre. Es posible tenerla sin grandes problemas, pero si entra en la sangre puede causar una infección muy grave", revela a Sputnik el especialista. Sin embargo, si no pasa al torrente sanguíneo, puede no molestar a su anfitrión demasiado.
Aunque hasta ahora ha habido solo unos 5.000 casos de infección en todo el mundo, la resistencia del hongo al tratamiento es lo que preocupa a los médicos.
"La 'Candida auris', en su mayoría, es resistente a los medicamentos que se utilizan para tratarla. Alrededor de un tercio de estas cándidas son resistentes al menos a un medicamento (...) y una cantidad puede ser resistente a más medicamentos, por lo que el tratamiento puede ser bastante complicado en algunas situaciones", destaca Werneck.
Otro problema es la dificultad que tienen los médicos y los laboratorios para identificar la presencia del hongo. La mayoría de los laboratorios no tienen las condiciones necesarias para identificar el hongo.
Sin embargo, a pesar de ser una enfermedad que preocupa a los organismos de salud y a los hospitales, la Cándida auris tiene una tasa de mortalidad que varía de una persona a otra.
"La tasa de mortalidad es muy variable y depende mucho de la gravedad de la enfermedad del paciente. No está claro cuánto añade este hongo al riesgo de muerte. En general, el riesgo se determina por la gravedad de la enfermedad del paciente", agregó Pasqualotto.
El hongo es más letal en pacientes que tienen otros problemas de salud, lo que facilita el desarrollo de la forma sanguínea que puede llevar a la muerte.
¿Puede llevar a una pandemia?
Pese a que la Candida auris puede transmitirse a otras personas por contacto, ya sea directo o por medio de un objeto, esto no significa que el mundo esté en riesgo de una pandemia parecida a la del COVID-19.
"Aunque este hongo se ha extendido por todo el mundo, sigue siendo una infección poco común que se limita a las personas vulnerables dentro de los hospitales. En un país tan grande como Brasil, solo un paciente fue diagnosticado, por lo que sigue siendo una infección muy inusual", resume Pasqualotto.